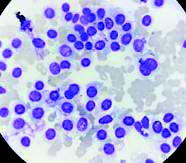
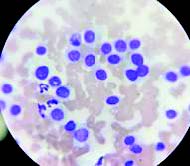
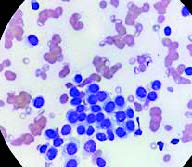

一般情况
| 品种 | 混种犬 |
| 年龄 | 12岁 |
| 性别 | 雌 |
| 是否绝育 | 否 |
| 诊断 | 组织细胞瘤 |
01 主诉及病史
因面部肿块就诊。
02 检查
面部有一巨大肿块(右侧延伸明显,左侧较轻),呈坏死状并伴有出血点(图1)。肿块直径约12-8厘米,累及右额骨、右鼻区及右上颌骨;左侧仅左鼻区受累。



图1. 右额及鼻部肿块大体照片(术前)。
采用18号针头进行细针穿刺抽吸取样并进行细胞学检查。染色后,细胞学检查可见多量无异型性的间充质细胞,包括圆形胞体、胞质空泡、染色质粗糙或核仁明显(图2)。背景中可见少量炎性细胞及大量红细胞。未观察到典型的细菌或真菌感染。

图2. 细胞学显示多个无异型性的间充质细胞,包括圆形细胞、胞质空泡、染色质粗糙或核仁明显者。
影像学表现为溶骨性膨胀性病变,伴增生性骨膜反应,边缘不规则,骨膜反应呈点状至柱状(图3)。肿瘤起始于鼻孔末端延伸至眼眶区域,与正常骨组织的过渡区界限不清。额骨、鼻骨及上颌骨可见明显破坏,提示为侵袭性骨病变。



图3. X线片示溶骨性膨胀性病变,伴增生性骨膜反应,边缘不规则,骨膜反应呈点状至柱状。
取自肿块吻端的活检样本显示,肿瘤中心为软骨组织,软骨细胞形态正常,未见恶性肿瘤;病理评估结果为组织细胞瘤。
03 治疗
随后行手术切除膨胀性肿瘤(图4为术后照片)。采用氯胺酮-地西泮(5 mg/kg、0.5 mg/kg)诱导全身麻醉,并以3% MAC异氟烷维持。术后给予广谱抗生素(头孢唑林20 mg/kg,q24h)及镇痛药(曲马多2 mg/kg)以预防感染并控制疼痛。

图4. 术后大体照片,显示愈合良好,组织损伤轻微。
肿块切片可见一界限清晰的区域,由片状圆形至多边形组织细胞构成;细胞胞质中等量、淡嗜伊红,核圆或卵圆形、居中或偏位,染色质细点状,核仁不明显。病变周边常可见轻至中度小淋巴细胞浸润(图5)。

图5. 细胞具有中等量淡嗜酸性胞质,核圆或卵圆形,居中或偏位,染色质细点状,核仁不明显。
04 预后
术后6个月,未见复发。
05 讨论
皮肤组织细胞瘤是一种起源于朗格汉斯细胞的良性皮肤肿瘤,常见于年轻犬,尤其是1~3岁的犬。该肿瘤通常表现为单发、圆形、无毛、生长迅速的结节,常见于头部、耳部或四肢。
大多数病例在数周至数月内可自行消退,属于自限性疾病。然而,在老年犬中发生巨大体积的组织细胞瘤较为罕见,且容易被误诊为恶性肿瘤,如鳞状细胞癌、黑色素瘤或肥大细胞瘤等。
组织细胞瘤的细胞学特征通常包括圆形或多边形的组织细胞样细胞,胞浆丰富,核呈圆形或卵圆形,染色质细腻,核仁不明显。免疫组化染色可进一步确认其来源,常见标志物包括CD1a(朗格汉斯细胞)和CD11c(树突状细胞)。
尽管该肿瘤为良性,但若体积巨大或位于面部重要结构附近,可能引发局部组织压迫、骨吸收甚至功能损害,需及时干预。
本例报告了一例12岁母犬,其前鼻骨区域出现一巨大组织细胞瘤,直径约10厘米,病程进展迅速。该病例在临床、影像学及病理学上均表现出一定复杂性,尤其在老年犬中较为罕见,增加了诊断难度。初步影像学检查显示该肿瘤伴随明显的骨破坏和骨膜反应,提示为侵袭性病变,因此需与多发性骨髓瘤、骨肉瘤、鳞状细胞癌等恶性肿瘤鉴别。
细胞学检查未见恶性特征,组织活检最终确诊为良性组织细胞瘤。尽管该肿瘤在病理上为良性,但其巨大体积及对周围骨组织的侵袭性表现提示,在某些情况下,组织细胞瘤可能表现出“局部侵袭性”生长行为,尤其在老年犬中更易出现非典型表现。
手术切除是治疗该病例的首选方式。术后病理结果证实为典型组织细胞瘤,未见恶性转化迹象,术后6个月未见复发,预后良好。值得注意的是,作者提到在术前曾有两次对该肿瘤的物理干预(如穿刺或挤压),可能刺激了肿瘤的快速生长。这提示临床操作中应尽量避免对不明肿瘤的反复刺激,以免诱发其异常增殖或炎症反应。
本病例强调了在老年犬中亦需将组织细胞瘤纳入皮肤肿物的鉴别诊断范围,尤其是当肿瘤体积巨大或伴随骨组织破坏时。尽管该肿瘤通常为良性,但在特殊情况下可能表现出局部侵袭性,需通过细胞学、影像学及组织病理学综合评估,避免误诊为恶性肿瘤。
此外,本病例亦提示,早期完整切除是治疗组织细胞瘤的有效手段,尤其在肿瘤影响到重要解剖结构或功能时,应及时手术干预。对于老年犬,术后仍需密切随访,观察有无复发或并发症发生。总之,组织细胞瘤虽为良性,但在临床表现上可能具有“伪装性”,尤其在老年犬中更需警惕其不典型表现。多学科的协作诊断和个体化治疗是确保良好预后的关键。未来仍需进一步研究老年犬组织细胞瘤的发病机制及其生物学行为,以指导更精准的诊疗策略。
文献来源:Nikzad R, Nemati-Nejad M, Tabarestani AA, Sahvieh S, Minaie MA, Ramezani M, Tavana M, Azizzadeh A. A case report of massive cutaneous histiocytoma in a 12-year-old intact bitch: Cytologic, radiologic, pathologic investigation. Open Vet J. 2025;15(10):5368-5372.